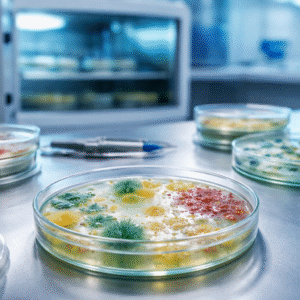
Microbiología

NOVALAB a través de su programa de evaluación externa de calidad QUALITEST – ha querido ofrecer un complemento al control de calidad interno, para ayudar a prevenir y detectar situaciones anómalas; así como a tomar las medidas correctivas pertinentes en caso necesario. Además promueve la calidad analítica entre los laboratorios.

Programa de Evaluación Externa de Calidad Externo “Qualitest – Control Nova”
El control de calidad es la base para desarrollar el enfoque de calidad total que se requiere en el laboratorio clínico. Sólo mediante un excelente control de calidad (interno y externo) en el laboratorio clínico, es posible garantizar que los resultados generados reflejen correctamente la realidad de nuestros pacientes.
Usuarios: Favor dirigirse a la página web www.novalab.com.co
Se presta asesoría de forma gratuita para Laboratorios inscritos a los programas Qualitest – Control Nova